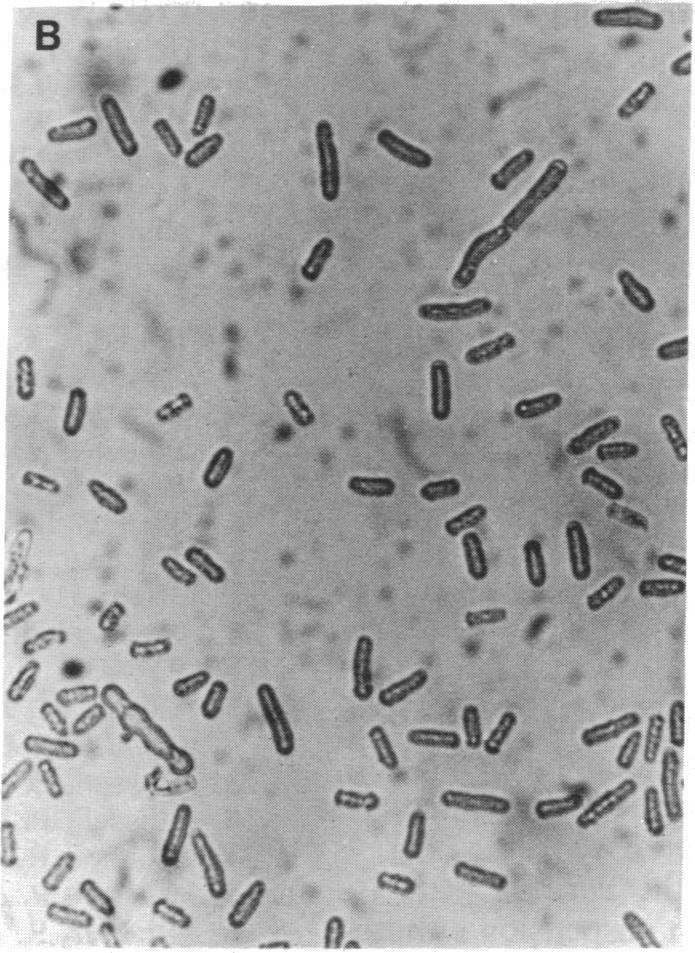

一种编码与p34cdc2同源的蛋白激酶的苜蓿cDNA对酵母细胞周期突变体的互补作用。
Complementation of a yeast cell cycle mutant by an alfalfa cDNA encoding a protein kinase homologous to p34cdc2.
作者信息
Hirt H, Páy A, Györgyey J, Bakó L, Németh K, Bögre L, Schweyen R J, Heberle-Bors E, Dudits D
机构信息
Institute of Microbiology and Genetics, University of Vienna, Austria.
出版信息
Proc Natl Acad Sci U S A. 1991 Mar 1;88(5):1636-40. doi: 10.1073/pnas.88.5.1636.
The cdc2 protein kinase plays a central role in control of the eukaryotic cell cycle of animals and yeasts. We have isolated a cDNA clone (cdc2Ms) from alfalfa (Medicago sativa L.) that is homologous to the yeast cdc2/CDC28 genes. The encoded protein is 64% identical to the yeast and mammalian counterparts and shows all the prominent structural features known from these organisms. Antibody raised against a 16-amino acid synthetic peptide with crossreactivity against p34 proteins recognized a 34-kilodalton protein in extracts of alfalfa cells. When transferred into a fission yeast, the plant cdc2 homolog can complement a temperature-sensitive cdc2 mutant. Northern analysis revealed higher transcript levels in shoots and suspension cultures than in roots. In addition to the dominant transcript of 1.4 kilobases detected in the poly(A)+fraction, 2.5- and 1.2-kilobase transcripts were detected in total RNA preparations from shoots or somatic embryos. Suspension cultures that were induced to form somatic embryos by an auxin (2,4-dichlorophenoxyacetic acid) showed fluctuations in transcription pattern during the induction period and embryogenesis.
细胞周期蛋白依赖性激酶2(cdc2)在动物和酵母的真核细胞周期调控中起着核心作用。我们从紫花苜蓿(Medicago sativa L.)中分离出一个与酵母cdc2/CDC28基因同源的cDNA克隆(cdc2Ms)。编码的蛋白质与酵母和哺乳动物的对应物有64%的同一性,并具有这些生物体中已知的所有显著结构特征。针对与p34蛋白有交叉反应的16个氨基酸合成肽产生的抗体,在紫花苜蓿细胞提取物中识别出一种34千道尔顿的蛋白质。当转入裂殖酵母中时,植物cdc2同源物可以互补温度敏感型cdc2突变体。Northern分析显示,茎和悬浮培养物中的转录本水平高于根。除了在poly(A)+组分中检测到的1.4千碱基的主要转录本外,在茎或体细胞胚的总RNA制备物中还检测到2.5千碱基和1.2千碱基的转录本。用生长素(2,4-二氯苯氧乙酸)诱导形成体细胞胚的悬浮培养物在诱导期和胚胎发生过程中表现出转录模式的波动。